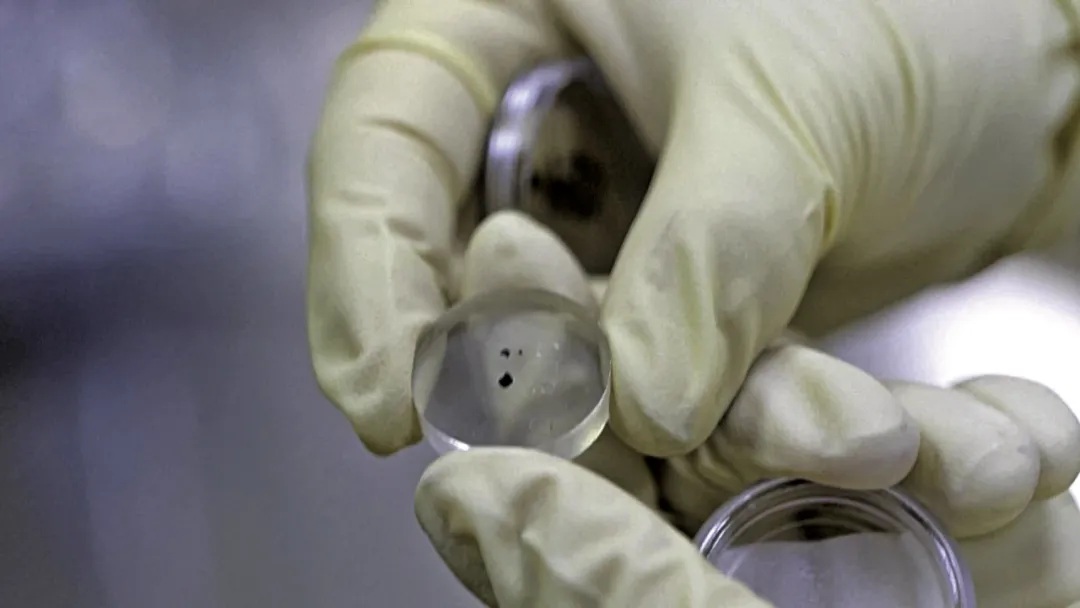

中国探月之路始于2004年,通过“绕、落、回”三步走战略,实现了从无到有、从跟跑到领跑的跨越:嫦娥一号、二号探测器成功实现绕月飞行,嫦娥三号、四号探测器分别实现了月球正面和背面的软着陆,嫦娥五号探测器成功完成月球采样返回任务,这标志着中国探月工程“绕、落、回”三步走战略完美收官。
嫦娥六号任务更是中国探月工程的重要延续。它成功着陆在月球背面南极-艾特肯盆地预选着陆区,并在月球背面采集了1935.3克珍贵样品。这些样品不仅为科学家提供了研究月球地质活动和演化过程的关键数据,还为验证月球岩浆洋模型提供了新的证据。
未来,嫦娥七号、嫦娥八号探测器将在月球南极区域建设国际月球科研站基本型,这是中国乃至全人类探索宇宙的又一重要里程碑。现在,人类基于已有的科学成果,正积极开展切实可行的目标化设计,迈向探索新高度。
月球基地什么样?这个问题激发了人们无限想象。而我国的探月工程四期任务,正在把想象一步步变为现实!

嫦娥四号探测器实现人类首次月球背面软着陆;首次获取月球背面南极-艾特肯盆地的地质数据,揭示月背古老撞击坑的演化历史。图为玉兔二号巡视器全景相机对嫦娥四号着陆器成像。

从月球背面南极-艾特肯盆地采集1935.3克月壤,实现人类首次月背采样返回。研究人员对月壤样品进行分析,首次揭示了月背约28亿年前仍存在年轻的岩浆活动,填补了月球玄武岩样品在该时期的记录空白;月背岩浆活动42亿年前就存在,至少持续了14亿年。这些研究为人们了解月球演化提供了关键科学证据。
【嫦娥七号探测器】
2026年前后发射。
将着陆月球南极,对月球极区的地形地貌、物质成分、空间环境进行综合探测。
部署探测器探测水冰分布与光照条件。
揭示水冰形成与保存机制,帮助人类了解月球水资源情况。
【嫦娥八号探测器】
2028年前后发射。
嫦娥八号将与嫦娥七号等共同构建国际月球科研站基本型。
验证月壤3D打印、机器人协同建造等原位资源利用技术。
实验月壤制氧、制砖技术,提高月球基地自给自足水平。
构建人类首个长期运行的月球基地,不仅是从“月球到达”迈向“月球驻留”的关键一步,更是人类探索深空的“跳板”。月球基地将成为人类在浩瀚宇宙中的新家园,继续承载无尽的梦想与希望。
责任编辑|高琳 岳焕琦
运营编辑|岳焕琦
质量审核 | 业蕾
文章来源 | 《知识是力量》杂志《海上生明月,九天揽星河——开启宇宙探索新征程》,作者/栾恩杰(中国工程院院士);《冲向月球基地》,撰文/贾阳(中国航天科技集团五院 航天科技设计师)。原文有删改,原创作品转载请注明来源。